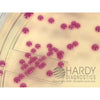
files/hardychrom_staph_g311_d175d598-0b94-4d3a-af2e-eac6e5792f6b.jpg

HardyCHROM™ Staphylococcus aureus, 15x100mm plate, Hardy Diagnostics
| Image | SKU | Description | Quantity | Price | Add to Cart |
|---|---|---|---|---|---|
|
G311 | HardyCHROM Staphylococcus aureus, 15x100mm plate | 10 Pack | $50 |
Description
HardyCHROM™ Staph aureus is a chromogenic medium recommended for the isolation, differentiation, and enumeration of Staphylococcus aureus by colony color. S. aureus has also been implicated in nosocomial infections and food poisoning outbreaks. Many S. aureus strains produce enterotoxins that cause food poisoning when ingested. Food poisoning, bacteremia, pneumonia, toxic shock syndrome, and meningitis are some of the more serious infections that can be caused by S. aureus.
Summary
Staphylococcus aureus is a gram-positive, coagulase-positive cocci that has been well documented as a human pathogen. S. aureus has also been implicated in nosocomial infections and food poisoning outbreaks. Many S. aureus strains produce enterotoxins that cause food poisoning when ingested. Food poisoning, bacteremia, pneumonia, toxic shock syndrome, and meningitis are some of the more serious infections that can be caused by S. aureus.
HardyCHROM™ Staph aureus allows for the rapid and reliable detection of S. aureus from both clinical and food specimens within 24 hours. Peptones in the medium supply the necessary nutrients. Selective agents inhibit the growth of gram-negative organisms, yeast, and some gram-positive cocci. Artificial substrates (chromogens) are broken down by specific microbial enzymes which release insoluble colored compounds.
S. aureus uses only one of the chromogens and will produce deep pink to fuchsia colored colonies. S. epidermidis and other coagulase negative species will be inhibited. Bacteria other than S. aureus that may appear may utilize the other chromogenic substrates and produce blue, white, or turquoise colonies. If none of the substrates are utilized, natural or white colored colonies will be present.
This medium can also be utilized in spread plate enumeration techniques.







